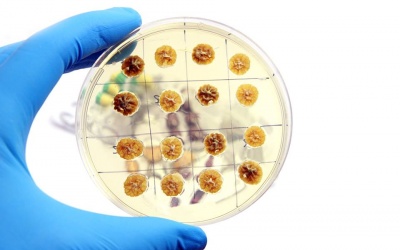
Infographic: Vi khuẩn kháng kháng sinh lây lan như thế nào?

Bắc Bộ mưa dông vài nơi, trời chuyển mát
17/04/2026 17:09
Theo Trung tâm Dự báo Khí tượng Thủy văn Quốc gia, từ ngày 18/4, nhiều nơi như Bắc Bộ, cao...
Dùng AI có làm đánh mất sự tự tin?
17/04/2026 16:52
Việc quá phụ thuộc vào trí tuệ nhân tạo (AI) đang âm thầm bào mòn niềm tin của con người vào...
Xây dựng đề án quản lý an toàn thực phẩm thống nhất toàn quốc
17/04/2026 14:26
Giữa bối cảnh thách thức về thực phẩm bẩn vẫn diễn biến phức tạp, Bộ trưởng Bộ Y...
10/08/2015 17:07
Bạc sulfadiazin là một trong những thuốc thường dùng để điều trị vết thương, vết bỏng.
10/08/2015 16:55
Cục Quản lý Dược vừa ra quyết định xử phạt vi phạm hành chính đối với Công ty TNHH MTV Saerom về hành vi ghi nhãn sản phẩm mỹ phẩm.
10/08/2015 15:43
Sẽ thế nào nếu chó có thể giúp người "đánh hơi" được ung thư, nhanh chóng và hiệu quả. Các bác sỹ ở Anh đã và đang làm được điều đó.
10/08/2015 15:08
Phụ nữ đến từ các quốc gia trên thế giới thực sự đã phải đối mặt với kỳ kinh nguyệt như thế nào? Những hủ tục nào vẫn còn tồn tại?
10/08/2015 14:55
Vi khuẩn kháng thuốc có thể lây lan một cách nhanh chóng. Khi tiếp xúc trực tiếp với người, động vật, thực phẩm, nước uống hoặc đồ vật có chứa vi khuẩn kháng thuốc, bạn đều có...
10/08/2015 11:54
Đường phố Đài Loan, Trung Quốc những ngày qua trở nên tan hoang khi bão Soudelor, cơn bão mạnh nhất năm đi qua với sức gió mạnh, mưa lớn, quật đổ hàng nghìn cây cối, làm hơn 8 người thiệt...
10/08/2015 11:53
Thịt lợn là thực phầm quen thuộc trong bữa ăn hàng ngày. Tuy nhiên, hiện nay thịt lợn bẩn đang được bày bán tràn lan khiến người dân canh cánh nỗi lo nhiễm bệnh ngay trên bàn ăn nhà mình.
10/08/2015 09:56
Đó là lời nhắn nhủ của Tổng Bí thư Nguyễn Phú Trọng với anh chị em làm báo tại Phiên chính thức của Đại hội lần thứ 10 Hội Nhà báo Việt Nam, diễn ra vào sáng ngày 9/8.
10/08/2015 08:43
Theo Trung tâm Dự báo Khí tượng Thuỷ văn Trung ương, hôm nay khu vực vùng núi Bắc Bộ có mưa rào rải rác và có nơi có dông. Gió nhẹ.
09/08/2015 20:01
Sẩy thai là điều mà bất cứ những ai sắp làm cha mẹ đều không mong muốn. Tuy nhiên, không may là có tới 10 - 25% bà bầu có nguy cơ bị sẩy thai trước khi bé được 20 tuần tuổi. Có 9 nguyên nhân...